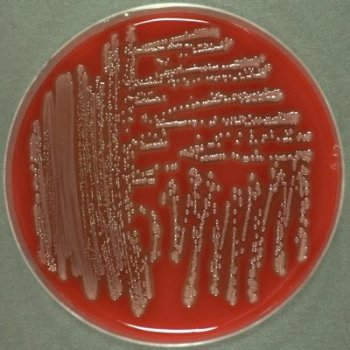
Gram-negative rods. Catalase-positive and oxidase-negative. Attacks sugars by fermentation and gas is produced. Motile. Mesophilic odour General Mesophilic Gram-negative have colonies Attacks and grey fermentation oxidase-negative

Gram-negative rods. Catalase-positive and oxidase-negative. Attacks sugars by fermentation and gas is produced. Motile. Mesophilic odour General Mesophilic Gram-negative have colonies Attacks and grey fermentation oxidase-negative
صفحه اصلی | پست الکترونیک | العربیه | English
امتیاز کاربران

Gram-negative rods. Catalase-positive and oxidase-negative. Attacks sugars by fermentation and gas is produced. Motile. Mesophilic odour General Mesophilic Gram-negative have colonies Attacks and grey fermentation oxidase-negative
